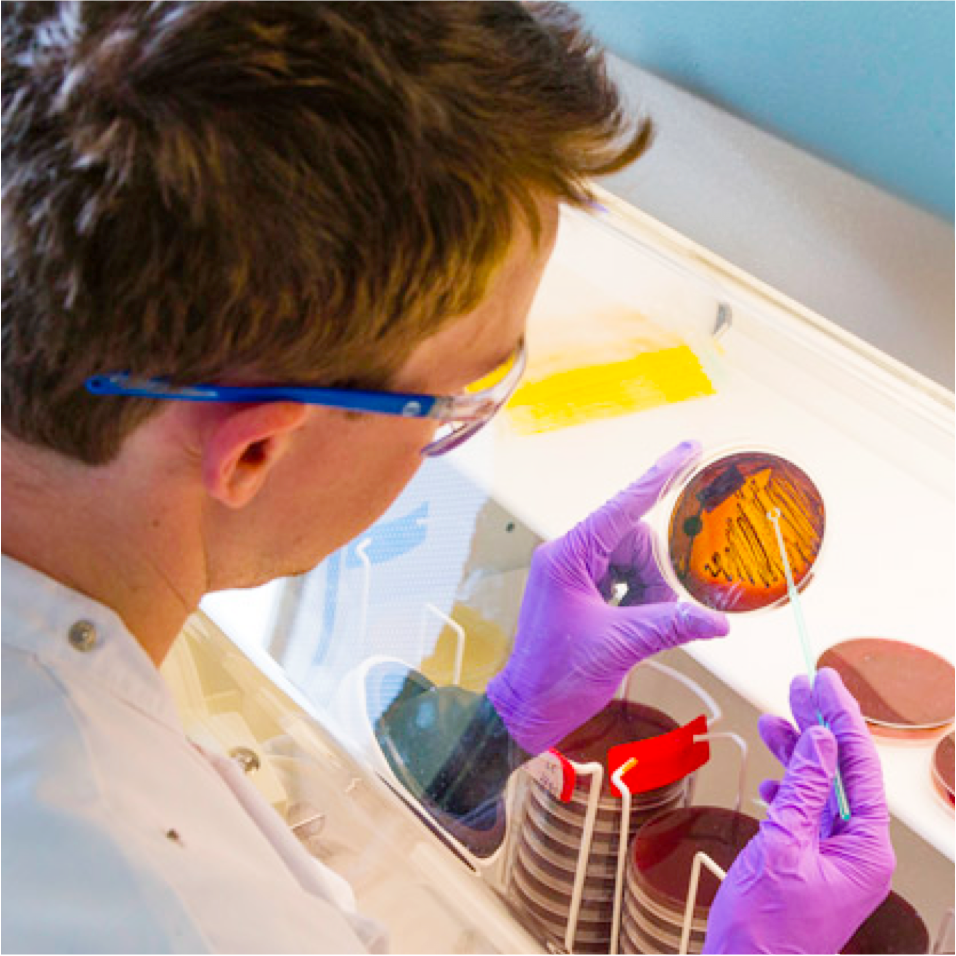
careers fpo image 1

Five Principles
Our Principles form the foundation of how we do business today and every day.
Overview
The Five Principles are how we do business at Mars
They unite us across geographies, cultures and generations. Together, they serve as a guide that every Associate can depend on to make decisions – big or small – knowing that when we look at a problem through the collective lens of the Five Principles, we will reach a stronger decision. They are at the heart of the success we’ve enjoyed over the decades and will continue to guide us in the decades to come.

We believe that the Five Principles guide us. They're part of our DNA. They really are the essence of Mars.

They're where everything starts—how we run the business, how we treat our customers, clients, suppliers, and all of our stakeholders. And they're how we effectively make some big and tough decisions.

The Five Principles are one of the reasons that I've been at Mars for so long. It's a cornerstone of what we’re all about and how we make decisions on a daily basis. It's a concept that makes me very proud to be part of Mars.

To me, the Five Principles mean making a better world for my son and for generations to come. It’s about building a happier society and a planet that is thriving.

Our rich heritage in science reflects the Five Principles. Embodying them in our work enables us to make exciting discoveries and create meaningful solutions that enrich the lives of people, pets and the planet.
Quality
Quality begins with delivering our best to the people and pets we serve.
It continues through all that we do.

Lifelong relationships with consumers and clients are hard to earn and easy to lose. We tirelessly seek to understand and satisfy their needs and deliver outstanding experiences of quality, safety and reliability. This is fundamental to our long-term success.
We hold ourselves to uncompromising standards and expect quality of one another. We’re energized to bring our personal best and work together as Associates, innovating and experimenting for fresh ideas and improved outcomes. Through collaboration with suppliers and customers, we aspire to continuously raise the bar.
The balance between benefits and affordability is an important driver for our consumers and clients. Part of delivering quality is ensuring the value we provide makes our products and services the preferred, trusted choice.

In Data and Analytics, quality is critical. Data is our raw material. We need to really focus on the brilliant quality of raw material to be able to deliver great outcomes.
Responsibility
We take responsibility without being asked.
We support the responsibilities of others.

Our Associate Concept applies to every person within Mars. It goes beyond treating everyone fairly and equitably; it’s about respecting and valuing our differences and ensuring that we all feel heard, appreciated and empowered.
Accountability is given; responsibility is something you feel. As Associates, we take initiative and make decisions based on our Principles.
When everyone takes ownership for doing the right thing and supports others to do the same, we all benefit. We’re action oriented. We excel through effective communication and efficient collaboration.

I think there's a really important distinction between ‘accountability’ and ‘responsibility’. We are given accountability, but responsibility is that feeling that you have inside you where you want to step up to the plate and bring solutions.
Mutuality
A mutual benefit is a shared benefit.
Shared benefits will endure.

Mutuality is a belief with powerful implications. It recognizes that we benefit when others gain too and compels us to think about others’ interests as well as our own. Creating enduring, shared benefits has been part of our success for more than a century.
We know that when benefits are mutual, the motivations are also shared. We look at every situation through the lens of building win-win relationships that create lasting benefits for our business, our Associates, our partners and society.
Mutuality is more critical today than ever. This is about asking how our business can be successful by creating more positive impact for our planet and its people.

I've always connected with this idea that we all have a vested interest in each other. It is incredibly human, and it's something that a lot of companies lack in their mission statements or in their guides. It’s very explicit here. It provides me with a test. Am I asking something of someone that I would ask of myself?
Efficiency
Our resources are precious.
Being efficient helps us accomplish more and waste less.

Our business depends upon the talent and energy of Associates, our financial and physical assets, planetary resources and more. Applying them efficiently helps us accomplish more, sustainably.
We benefit from sharing resources and learning from one another rather than reinventing the wheel each time. We seek to simplify how we’re organized to empower people and accelerate decision making.
We seek to continuously improve our quality, processes, technologies and ways of working. We’re candid about what we do best and what needs to be better. Collaboration with partners help us explore areas beyond our expertise and achieve more than we can on our own.

When we talk about efficiency, our definition is much wider than not wasting money, because we also don't want to waste the planet's resources.
Freedom
Freedom lets us shape our future.
Performance allows us to remain free.

Our financial freedom means we can think across generations, not quarters. It enables us to make choices that balance the needs of today with our aspirations for tomorrow.
We believe Purpose-led businesses perform better and have a positive impact on the world. This inspires us and our actions every day.
Our private ownership is a commitment. Independence allows us to act boldly to shape our future.

One of the things about freedom is that it allows you to go and execute your intention.

Careers
Careers at Mars
We’re transforming how we do business today so that we can continue being a positive force for people, pets and the planet tomorrow.


_06aa8.png?h=b02ac120&itok=kPGQSjs3)